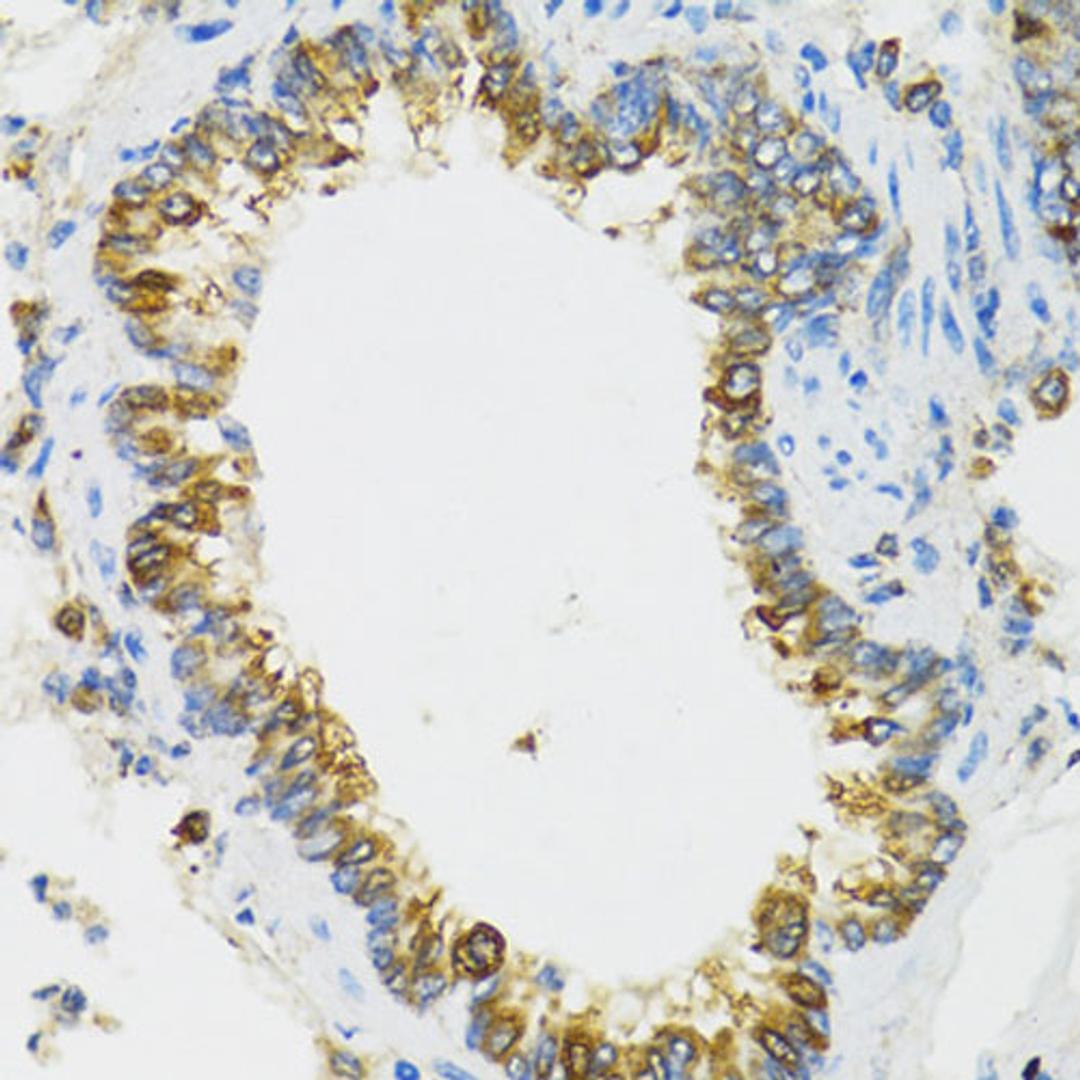
Immunohistochemistry - PI3 antibody (A12482)

Product & ReviewsAntibodies
PI3 Rabbit pAb
Product Details
- Cat. No.
- A12482
- Type
- Primary Antibody
- Clonality
- Polyclonal
- Host
- Rabbit

The supplier does not provide quotations for this antibody through SelectScience. You can search for similar antibodies in our Antibody Directory.
Description
This gene encodes an elastase-specific inhibitor that functions as an antimicrobial peptide against Gram-positive and Gram-negative bacteria, and fungal pathogens. The protein contains a WAP-type four-disulfide core (WFDC) domain, and is thus a member of the WFDC domain family. Most WFDC gene members are localized to chromosome 20q12-q13 in two clusters: centromeric and telomeric. This gene belongs to the centromeric cluster. Expression of this gene is upgulated by bacterial lipopolysaccharides and cytokines.
Biological Information
- Clonality: Polyclonal
- Host: Rabbit
- Reactivity: Human, Rat